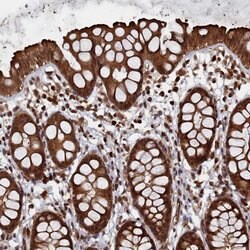
Invitrogen PIGN Polyclonal Antibody 100 &mu;L | Buy Online | Invitrogen&trade; | Fisher Scientific

missing translation for 'onlineSavingsMsg'
Learn More
Learn More
Description
Immunogen sequence: SWGISHTRVP TESRPGHVAL IAGFYEDVSA VAKGWKENPV EFDSLFNESK YTWSWGSPDI LPMFAKGASG DHVYTYSYDA KREDFGAQDA TKLDTW Highest antigen sequence identity to the following orthologs: Mouse - 97%, Rat - 97%.
PIGN is involved in glycosylphosphatidylinositol (GPI)-anchor biosynthesis. The GPI-anchor is a glycolipid found on many blood cells and serves to anchor proteins to the cell surface. This protein is expressed in the endoplasmic reticulum and transfers phosphoethanolamine (EtNP) to the first mannose of the GPI anchor.

Specifications
Specifications
| Antigen | PIGN |
| Applications | Immunohistochemistry (Paraffin), Immunocytochemistry |
| Classification | Polyclonal |
| Concentration | 0.4 mg/mL |
| Conjugate | Unconjugated |
| Formulation | PBS with 40% glycerol and 0.02% sodium azide; pH 7.2 |
| Gene | PIGN |
| Gene Accession No. | O95427 |
| Gene Alias | Gm20308; GPI ethanolamine phosphate transferase 1; MCAHS; MCAHS1; MCD4; MCD4 homolog; MDC4; phosphatidylinositol glycan anchor biosynthesis class N; phosphatidylinositol glycan anchor biosynthesis, class N; phosphatidylinositol glycan, class N; phosphatidylinositol-glycan biosynthesis class N protein; PIGN; PIG-N |
| Gene Symbols | PIGN |
| Show More |
Product Title
By clicking Submit, you acknowledge that you may be contacted by Fisher Scientific in regards to the feedback you have provided in this form. We will not share your information for any other purposes. All contact information provided shall also be maintained in accordance with our Privacy Policy.
Spot an opportunity for improvement?